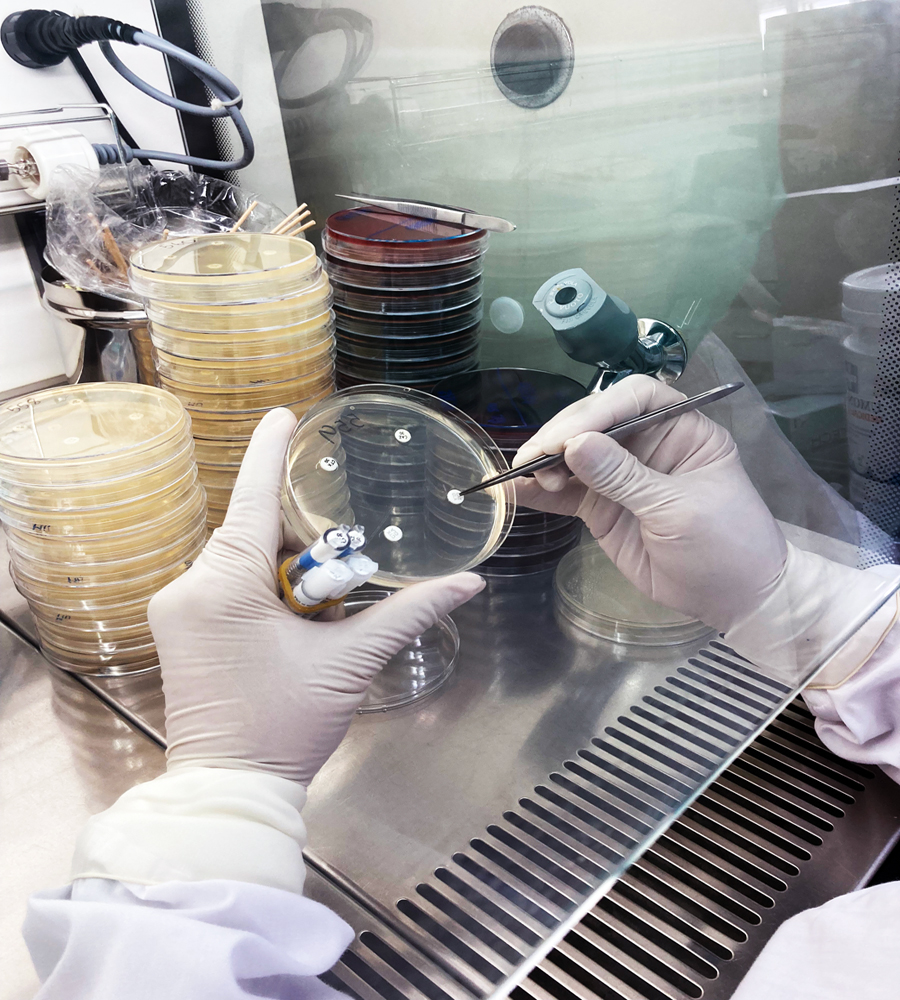
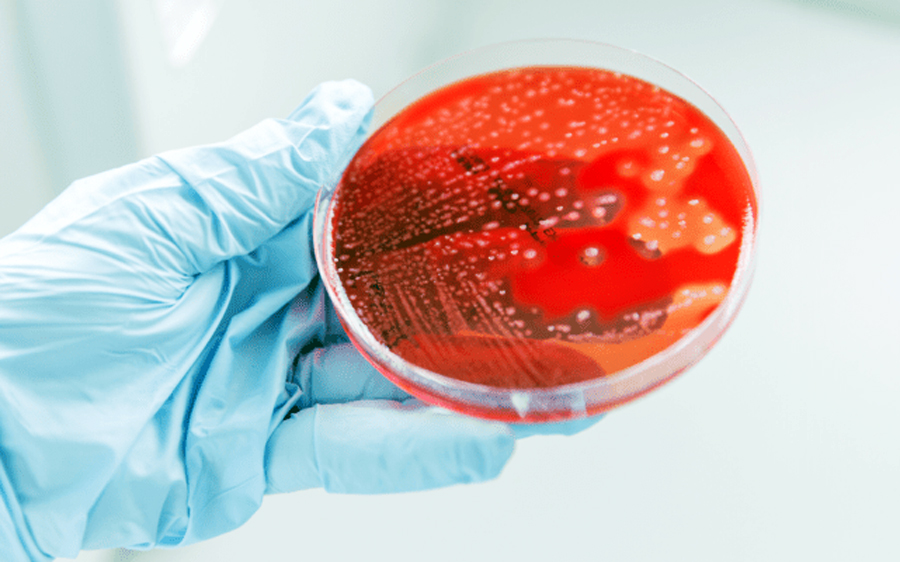

นายแพทย์ยงยศ ธรรมวุฒิ อธิบดีกรมวิทยาศาสตร์การแพทย์ กล่าวถึง โรคไข้อีดำอีแดง ว่าเป็นโรคโบราณที่อุบัติซ้ำกลับมาใหม่ หลายคนอาจไม่รู้จักและเข้าใจผิดกันอยู่ จนทำให้เกิดโรคลุกลามและแทรกซ้อนได้ โรคไข้อีดำอีแดงเกิดจากการติดเชื้อแบคทีเรียสเตรปโตคอคคัส กรุ๊ปเอ (Group A Streptococcus) หรือ Streptococcus pyogenes ซึ่งเป็นเชื้ออยู่ในลำคอ สามารถพบคนที่เป็นพาหะเชื้อนี้ได้ร้อยละ 10-20 เชื้อนี้มีช่องทางการติดต่อโดยการหายใจ สูดละอองฝอยน้ำลาย หรือการสัมผัสสารคัดหลั่งของผู้ติดเชื้อ มักพบในเด็กเล็กจนถึงวัยเรียน อายุ 5-15 ปี โดยหากติดเชื้อจะมีไข้สูง หนาวสั่น เจ็บคอ กลืนลำบาก มีผื่นแดงหยาบคล้ายกระดาษทราย (sandpaper-like rash) มักเริ่มจากหน้าอก ลำตัว แล้วลามไปทั่วร่างกาย มีลิ้นสีแดงคล้ายสตรอว์เบอร์รี (Strawberry tongue) และอาจทำให้เกิดภาวะแทรกซ้อนสำคัญคือ โรคหัวใจรูมาติก (Rheumatic Fever) หรือไตอักเสบ โรคไข้อีดำอีแดง ไม่ใช่โรคร้ายแรง สามารถรักษาให้หายขาดได้ โดยรักษาได้ด้วยยาปฏิชีวนะ ได้แก่ Penicillin หรือ Amoxycillin หรือ Erythromycin จนครบ 10 วัน เพื่อป้องกันการเกิดโรคไข้รูมาติกและไตอักเสบแทรกซ้อน

นายแพทย์ยงยศ กล่าวต่ออีกว่า การป้องกันและการลดโอกาสเกิดการติดเชื้อในเด็ก ผู้ปกครองควรสังเกตผื่นแดงร่วมกับอาการไข้ที่เกิดขึ้นกับบุตรหลาน ไม่ใช่ผื่นจากอาการแพ้ แต่เป็นผื่นจากโรคมากกว่า เพื่อจะได้รีบพาไปพบแพทย์รับการตรวจวินิจฉัยและรับการรักษาที่เหมาะสมต่อไป หากเด็กป่วยให้หยุดเรียน
เพื่อป้องกันการแพร่เชื้อให้เด็กคนอื่น นอกจากนี้การล้างมือเป็นวิธีสำคัญในการป้องกันการแพร่เชื้อ โดยเฉพาะหลังไอ จาม หรือ ก่อนจับอาหาร ควรปิดปากขณะไอ จาม ไม่ใช้แก้วน้ำ ช้อน ผ้าเช็ดหน้าร่วมกัน ก็เป็นการป้องกันที่ดี รวมทั้งการแยกภาชนะของผู้ป่วย การแยกซักล้างเครื่องใช้ส่วนตัวก็ถือเป็นเรื่องสำคัญเช่นกัน
“สำหรับการส่งตรวจทางห้องปฏิบัติการ กรมวิทยาศาสตร์การแพทย์ โดย สถาบันวิจัยวิทยาศาสตร์สาธารณสุข เปิดให้บริการตรวจเกี่ยวกับเชื้อ S. pyogenes ดังนี้ 1.การเพาะแยกเชื้อแบคทีเรีย S. pyogenes จากสิ่งส่งตรวจ ได้แก่ Throat swab, Nasopharyngeal swab ใน Stuart transport media หรือ Amies transport media ขนส่งที่อุณหภูมิห้อง 2. ตรวจยืนยันตัวอย่างเชื้อบริสุทธิ์บน Blood agar หรือ Dorset egg slant ขนส่งที่อุณหภูมิห้อง

ทั้งนี้ สามารถติดต่อสอบถามเพิ่มได้ที่ศูนย์รวมบริการ กรมวิทยาศาสตร์การแพทย์ โทรศัพท์ 0 2951 0000 ต่อ 98328 และศูนย์เฝ้าระวังและประสานงานทางห้องปฏิบัติการ สถาบันวิจัยวิทยาศาสตร์สาธารณสุข กรมวิทยาศาสตร์การแพทย์ โทร 0 2951 0000 ต่อ 99248 หรือแอดไลน์ที่ Line Official account : @769baxtr” นายแพทย์ยงยศ กล่าวทิ้งท้าย
ข่าวประชาสัมพันธ์เกี่ยวข้อง
แผนผังเว็บไซต์
- นโยบายธรรมภิบาล
- ภารกิจ และหน้าที่รับผิดชอบของหน่วยงาน
- วิสัยทัศน์ & พันธกิจ & ยุทธศาสตร์
- ประวัติความเป็นมา
- นโยบายคุณภาพ
- แผนกลยุทธ์กรมวิทยาศาสตร์การแพทย์
- แผนการปฏิบัติราชการและ แผนการใช้จ่ายงบประมาณ
- โครงสร้างหน่วยงาน
- ทำเนียบผู้บริหาร
- ทำเนียบผู้ทรงคุณวุฒิ
- ซีไอโอ
- เว็บไซต์ส่วนกลาง
-
- สถาบันวิจัยวิทยาศาสตร์สาธารณสุข
- สถาบันชีววิทยาศาสตร์ทางการแพทย์
- สำนักงานคณะกรรมการพิจารณาการศึกษาวิจัยในคน
- สำนักงานเลขานุการกรม
- กลุ่มงานจริยธรรม
- กลุ่มตรวจสอบภายใน
- กลุ่มพัฒนาระบบบริหาร
- กองความร่วมมือระหว่างประเทศ
- กองประชาสัมพันธ์และสื่อสารสาธารณะ
- กองทดสอบความชำนาญ
- กองแผนงานและวิชาการ
- กองบริหารทรัพยากรบุคคล
- ศูนย์รวมบริการ
- ศูนย์เทคโนโลยีสารสนเทศและการสื่อสาร
- สถาบันชีววัตถุ
- สถาบันวิจัยสมุนไพร
- สำนักเครื่องสำอางและวัตถุอันตราย
- สำนักคุณภาพและความปลอดภัยอาหาร
- สำนักมาตรฐานห้องปฏิบัติการ
- สำนักยาและวัตถุเสพติด
- สำนักรังสีและเครื่องมือแพทย์
- สำนักผู้ทรงคุณวุฒิกรมวิทยาศาสตร์การแพทย์
- เว็บไซต์ส่วนภูมิภาค
-
- ศูนย์วิทยาศาสตร์การแพทย์ที่ 1 เชียงใหม่
- ศูนย์วิทยาศาสตร์การแพทย์ที่ 1/1 เชียงราย
- ศูนย์วิทยาศาสตร์การแพทย์ที่ 2 พิษณุโลก
- ศูนย์วิทยาศาสตร์การแพทย์ที่ 3 นครสวรรค์
- ศูนย์วิทยาศาสตร์การแพทย์ที่ 4 สระบุรี
- ศูนย์วิทยาศาสตร์การแพทย์ที่ 5 สมุทรสงคราม
- ศูนย์วิทยาศาสตร์การแพทย์ที่ 6 ชลบุรี
- ศูนย์วิทยาศาสตร์การแพทย์ที่ 7 ขอนแก่น
- ศูนย์วิทยาศาสตร์การแพทย์ที่ 8 อุดรธานี
- ศูนย์วิทยาศาสตร์การแพทย์ที่ 9 นครราชสีมา
- ศูนย์วิทยาศาสตร์การแพทย์ที่ 10 อุบลราชธานี
- ศูนย์วิทยาศาสตร์การแพทย์ที่ 11 สุราษฎร์ธานี
- ศูนย์วิทยาศาสตร์การแพทย์ที่ 11/1 ภูเก็ต
- ศูนย์วิทยาศาสตร์การแพทย์ที่ 12 สงขลา
- ศูนย์วิทยาศาสตร์การแพทย์ที่ 12/1 ตรัง
- กฏหมาย ระเบียบ และข้อบังคับที่เกี่ยวข้อง
- รายงานประจำปี











